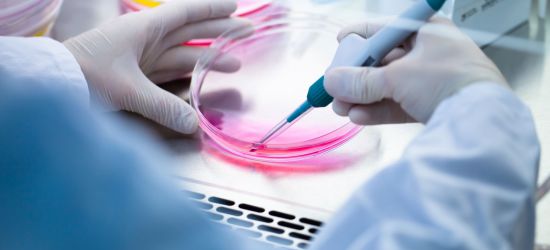
Matične ćelije čuvanje

Tamara Dragičević sačuvala matične ćelije!
Glumci Tamara Dragičević i Petar Benčina jedan su od mnogobrojnih parova koji su, saznavši da će postati roditelji, odlu[...]
15 Decembar 2016

Glumci Tamara Dragičević i Petar Benčina jedan su od mnogobrojnih parova koji su, saznavši da će postati roditelji, odlu[...]
15 Decembar 2016

Najnovija istraživanja iz oblasti regenerativne medicine ispituju širok spektar mogućnosti za primenu matičnih ćelija. O[...]
01 Decembar 2016
Na samom početku razvoja oblasti čuvanja matičnih ćelija, matične ćelije su se čuvale u punoj krvi, ali brzim razvojem t[...]
29 Septembar 2016